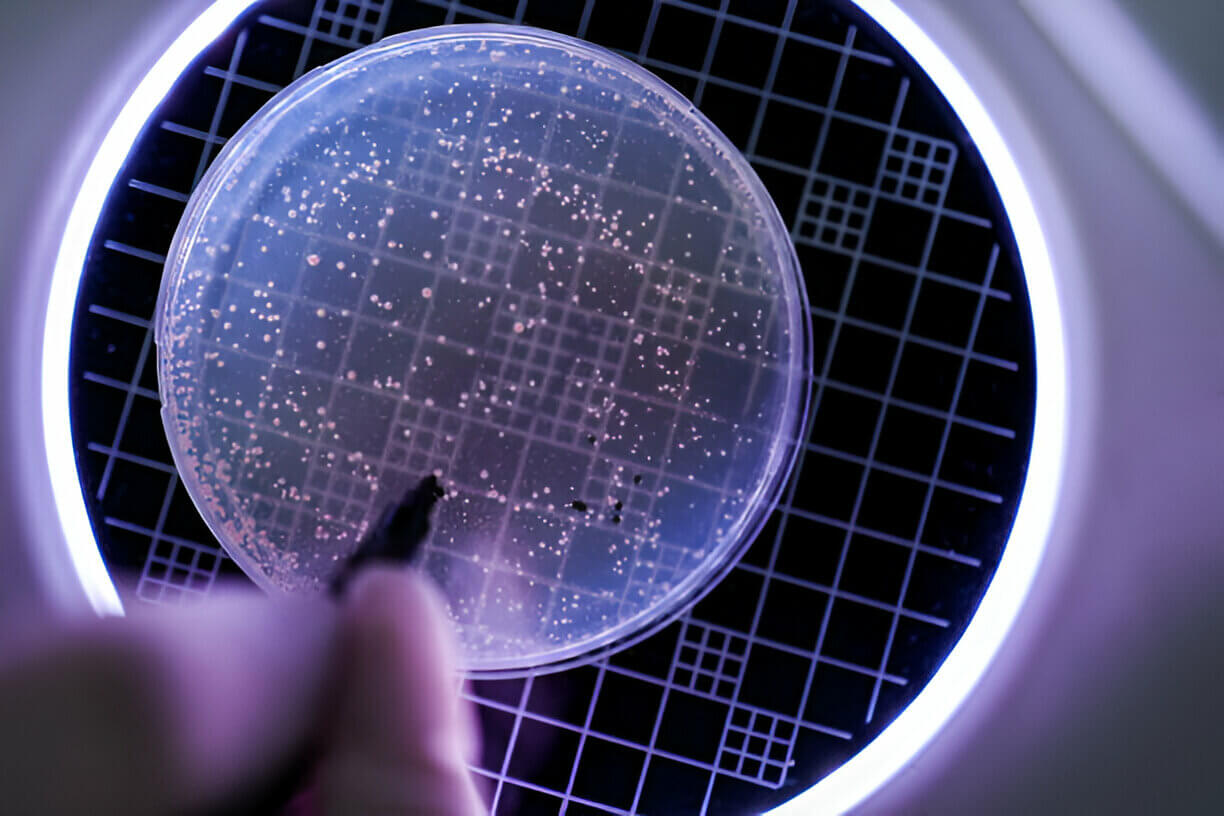
手持装有细菌培养基的培养皿

不同的微生物有不同的营养需求,但所有微生物的生长都需要碳、氮和微量元素。在实验室中,我们使用培养基来提供这些营养物质。
培养基主要有两种:
1. 化学定义或合成培养基: 这些培养基有已知的确切成分。
2. 非合成培养基: 这些介质有一些未知成分。
大多数微生物试验都使用非合成培养基。合成培养基通常只用于特殊实验或研究。
有些微生物可以在仅含氮或硝酸盐的简单培养基中生长。其他微生物则需要蛋白胨(一种蛋白质消化物)等更复杂的成分作为氮源。在临床环境中发现的大多数微生物需要更复杂的化合物才能生长良好。
培养基可根据其目的或功能分为几种类型:
I. 富集培养基
这类培养基添加了血液、血清或动物/植物提取物等特殊营养物质,以支持耐药菌的生长。例如
血液琼脂平板(BAP): 支持肺炎链球菌的生长。
✅布鲁氏菌琼脂(或 AnBAP): 支持厌氧菌生长。
巧克力琼脂:支持流感嗜血杆菌的生长。其他富集培养基包括胰蛋白酶大豆琼脂(TSA)、胰蛋白酶大豆肉汤(TSB)、TGEA、平板计数琼脂(PCA)、营养琼脂(NA)、LB 琼脂和 Mueller-Hinton 琼脂(M-H)。
II. 选择性培养基
这些培养基含有特定的化学物质,可抑制一类细菌的生长,同时允许另一类细菌繁殖。例如:
✅亚甲蓝(EMB)培养基和麦康凯(MacConkey)培养基: 允许革兰氏阴性杆菌(如大肠杆菌)生长,但抑制革兰氏阳性球菌(如葡萄球菌)。
✅含抗生素的分离培养基(如 CAN): 选择性抑制某些微生物(肠杆菌),同时允许特定微生物(葡萄球菌)良好生长。
III. 差异培养基
这些培养基含有特殊的化学物质,可使不同的细菌表现出不同的特性。例如:
✅麦康凯培养基: 乳糖发酵革兰氏阴性杆菌形成粉红色菌落,而非乳糖发酵菌形成无色菌落。
✅EMB琼脂: 乳糖发酵菌形成深紫色或蓝黑色菌落,而非发酵菌形成无色菌落。麦康凯琼脂和 EMB 琼脂均可作为鉴别和选择培养基。血琼脂平板(BAP)可区分溶血性和非溶血性细菌,因此既是富集培养基,也是鉴别培养基。
IV. 富集培养基
这些培养基含有特殊成分,有利于所需细菌种类的生长,同时抑制其他细菌的生长。它们通常用于从样本中分离生长缓慢或数量较少的菌种。例如:
✅GN肉汤和硒酸盐亮绿肉汤: 用于粪便样本微生物检查,促进沙门氏菌的生长,同时抑制大肠杆菌等常见细菌。
✅碱性蛋白胨水: 由于 pH 值较高,可促进霍乱弧菌的生长,同时抑制其他细菌。
V. 鉴定细菌特征的培养基
a) 碳水化合物发酵试验培养基:
- 例如 含 1%乳糖的溴甲酚紫肉汤、含 1%碳水化合物的 CTA、含 1%碳水化合物的酚红肉汤、含 1%碳水化合物的安德拉德肉汤、含 1%碳水化合物的 O/F 肉汤。
b) 底物利用试验培养基:
- 例如 柠檬酸琼脂(Simmons Citrate Agar)、醋酸琼脂(Acetate Agar)。
c) 产酶能力试验培养基:
- 例如:DNase 试验培养基、克里斯滕森琼脂: DNase 试验培养基、克里斯滕森尿素琼脂、鸟氨酸或赖氨酸脱羧酶培养基。
d) 特殊代谢物检测培养基:
- 例如:甲基红、VP 培养基: 甲基红、VP 培养基。
e) 运动能力检测培养基:
- 例如:运动试验培养基: 运动试验培养基。
f) 变色琼脂:
- 例如 用于检测各种病原体的 CHROMagar 系列。
VI. 保存和运送培养基
这些培养基用于保持纯培养物的活力和生理特性,例如:
储存培养基:用于保存普通肠杆菌。
✅GermBank 保存装置: 用于保存各种病原体。
运送培养基对于临床标本至关重要,可在培养前保持微生物种群不生长或减少。示例包括:
✅需氧培养棉签(含 Stuart、Amies 或 Cary-Blair 培养基)
✅厌氧培养皿或厌氧转管
✅缓冲甘油-碱性培养基(用于从粪便中分离志贺氏菌属)
✅弯曲菌管(用于从粪便中分离弯曲菌属)
转运培养基的优点(以艾米斯和斯图尔特为例):
1. 无营养物质--微生物不会繁殖。
2. 缓冲半固体琼脂 - 保持拭子水分和适当的 pH 值。
3. 含还原剂巯基乙酸钠。
4. 活性炭(如需要)--去除有毒代谢物,但可能会干扰涂片观察。
文章为麦瑞科林原创,如需转载,请注明文章链接和出处。